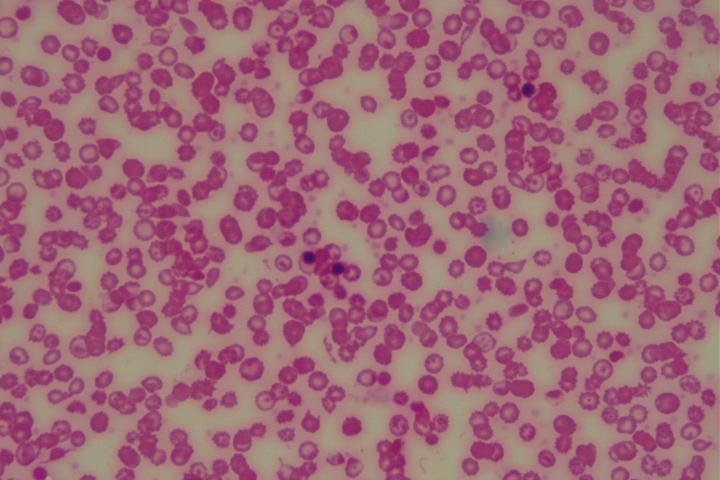

Todo lo que deberíamos saber sobre las anemias
No todas las anemias son iguales.
Por Victoriano Mulero Méndez, catedrático de Biología Celular, Universidad de Murcia; Ana B. Perez-Oliva, JIN-Mineco Researcher, Universidad de Murcia; Diana García-Moreno, Universidad de Murcia; y María Luisa Cayuela Fuentes, investigadora del Instituto Murciano de Investigación Biosanitaria (IMIB), Universidad de Murcia:
La anemia no es otra cosa que una falta de glóbulos rojos, esto es, las células de la sangre que transportan el oxígeno a todos los tejidos y órganos del organismo. Se trata de una patología tan frecuente que, según la Organización Mundial de Salud, afecta a 1 620 millones de personas, lo que representa un 24,8 % de la población mundial. Además, supone un importante gasto público para los sistemas de salud.
Para entender por qué se producen los glóbulos rojos, conviene hacer un repaso a su breve vida. Nacen en un tejido localizado en el interior de los huesos, denominado médula ósea, y tienen una vida media de 4 meses.
Se producen a partir de células madre hematopoyéticas que se generan en el desarrollo embrionario, responsables de formar todas las células sanguíneas durante la vida del organismo. Para hacernos una idea de la enorme capacidad de las células madre hematopoyéticas de producir células sanguíneas basta decir que producen 2 millones de glóbulos rojos cada segundo. A pesar de eso, existen varias situaciones que desembocan en una escasez de glóbulos rojos.
Aunque existen muchos tipos de anemia, la más común se produce por falta de hierro y se denomina anemia ferropénica. El hierro es un metal presente en la proteína mayoritaria de los glóbulos rojos, la hemoglobina, que es ni más ni menos que la encargada de unir el oxígeno y transportarlo desde los pulmones hasta el resto de tejidos.
Se trata de un nutriente esencial en nuestra alimentación que no suele eliminarse del organismo, a no ser que haya una hemorragia. Por ello, la anemia ferropénica es más habitual en las mujeres en edad fértil, que pierden grandes cantidades de sangre durante la menstruación. Y se trata con suplementos de hierro.
Otras anemias se deben a falta de vitaminas importantes para la formación de los glóbulos rojos, como la vitamina B12, y también las hay que tienen su origen en defectos genéticos y son hereditarias. Es el caso de la talasemia y la anemia falciforme, en las que se producen hemoglobinas defectuosas; la anemia de Fanconi, que se debe a defectos en la reparación del ADN; y la anemia de Diamond-Blackfan e inducida por cáncer.
En estas últimas tenemos puesto el foco en nuestro grupo de investigación. La anemia de Diamond-Blackfan es una anemia hereditaria que afecta solo a 4-5 personas por cada millón, por lo que se clasifica como enfermedad rara o poco frecuente. Los pacientes afectados por esta enfermedad presentan mutaciones en los genes responsables de producir los ribosomas, las fábricas donde se producen todas las proteínas celulares.
Lo que sucede es que la deficiente función de los ribosomas afecta mayoritariamente a una proteína esencial en la formación de los glóbulos rojos, el factor de transcripción GATA1.
GATA1 es imprescindible para que se formen los glóbulos rojos a partir de las células madre hematopoyéticas. De ahí que la escasez de GATA1 en estos enfermos conduzca a una deficiente formación de glóbulos rojos, y la consiguiente anemia. Este tipo de anemia no tiene tratamientos efectivos en la actualidad.
Otro tipo de anemia que tenemos muy presente es la asociada a enfermedades crónicas, entre ellas el cáncer. Se asocia a una retención de hierro por parte de las células encargadas de eliminar los glóbulos rojos envejecidos, los macrófagos.
Los macrófagos del bazo y del hígado, además de ser células importantes en combatir las infecciones, se encargan de eliminar los glóbulos rojos envejecidos, digerir su hemoglobina y liberar el hierro que contiene para que las células madre hematopoyéticas puedan formar nuevos glóbulos rojos.
Al menos eso es lo normal. Sin embargo, las enfermedades inflamatorias y el cáncer activan tanto a los macrófagos que impiden que liberen el hierro. En consecuencia, estas anemias no suelen curarse con suplementos de hierro, porque los macrófagos lo secuestran. Al final, no queda otra que recurrir a las transfusiones de sangre.
Usando como modelo animal de investigación el pez cebra, nuestro grupo de investigación ha demostrado recientemente que el inflamasoma, un conjunto de proteínas del macrófago implicadas en activar la inflamación, es capaz de destruir la proteína GATA1. Eso implica que, en enfermedades crónicas en las que el inflamasoma está hiperactivo, la cantidad de GATA1 se reduce mucho, lo que podría contribuir a desencadenar anemia y explicar que ésta no responda a suplementos de hierro.
Es decir, la anemia asociada a inflamación crónica y la anemia de Diamond-Blackfan comparten la deficiencia en GATA1, generada por causas diferentes. Y ambas podrían ser tratadas con inhibidores del inflamasoma para elevar GATA1. Como demuestran los resultados obtenidos por nuestro grupo de investigación en los modelos de pez cebra desarrollados de estas dos enfermedades.
Gracias a los proyectos financiados por la Fundación Séneca-Agencia de Ciencia y Tecnología de la Región de Murcia, el Ministerio de Ciencia e Innovación y a la Fundación de Anemia de Diamond-Blackfan americana, nuestro grupo está trabajando en dos aspectos del problema:
Por un lado, en evaluar la eficacia de los inhibidores del inflamasoma en el tratamiento de estos tipos de anemia usando células humanas.
Por otro, profundizando en los mecanismos implicados en la regulación de la formación de los glóbulos rojos por el inflamasoma, con el fin de identificar nuevas dianas terapéuticas y desarrollar tratamientos más efectivos.
